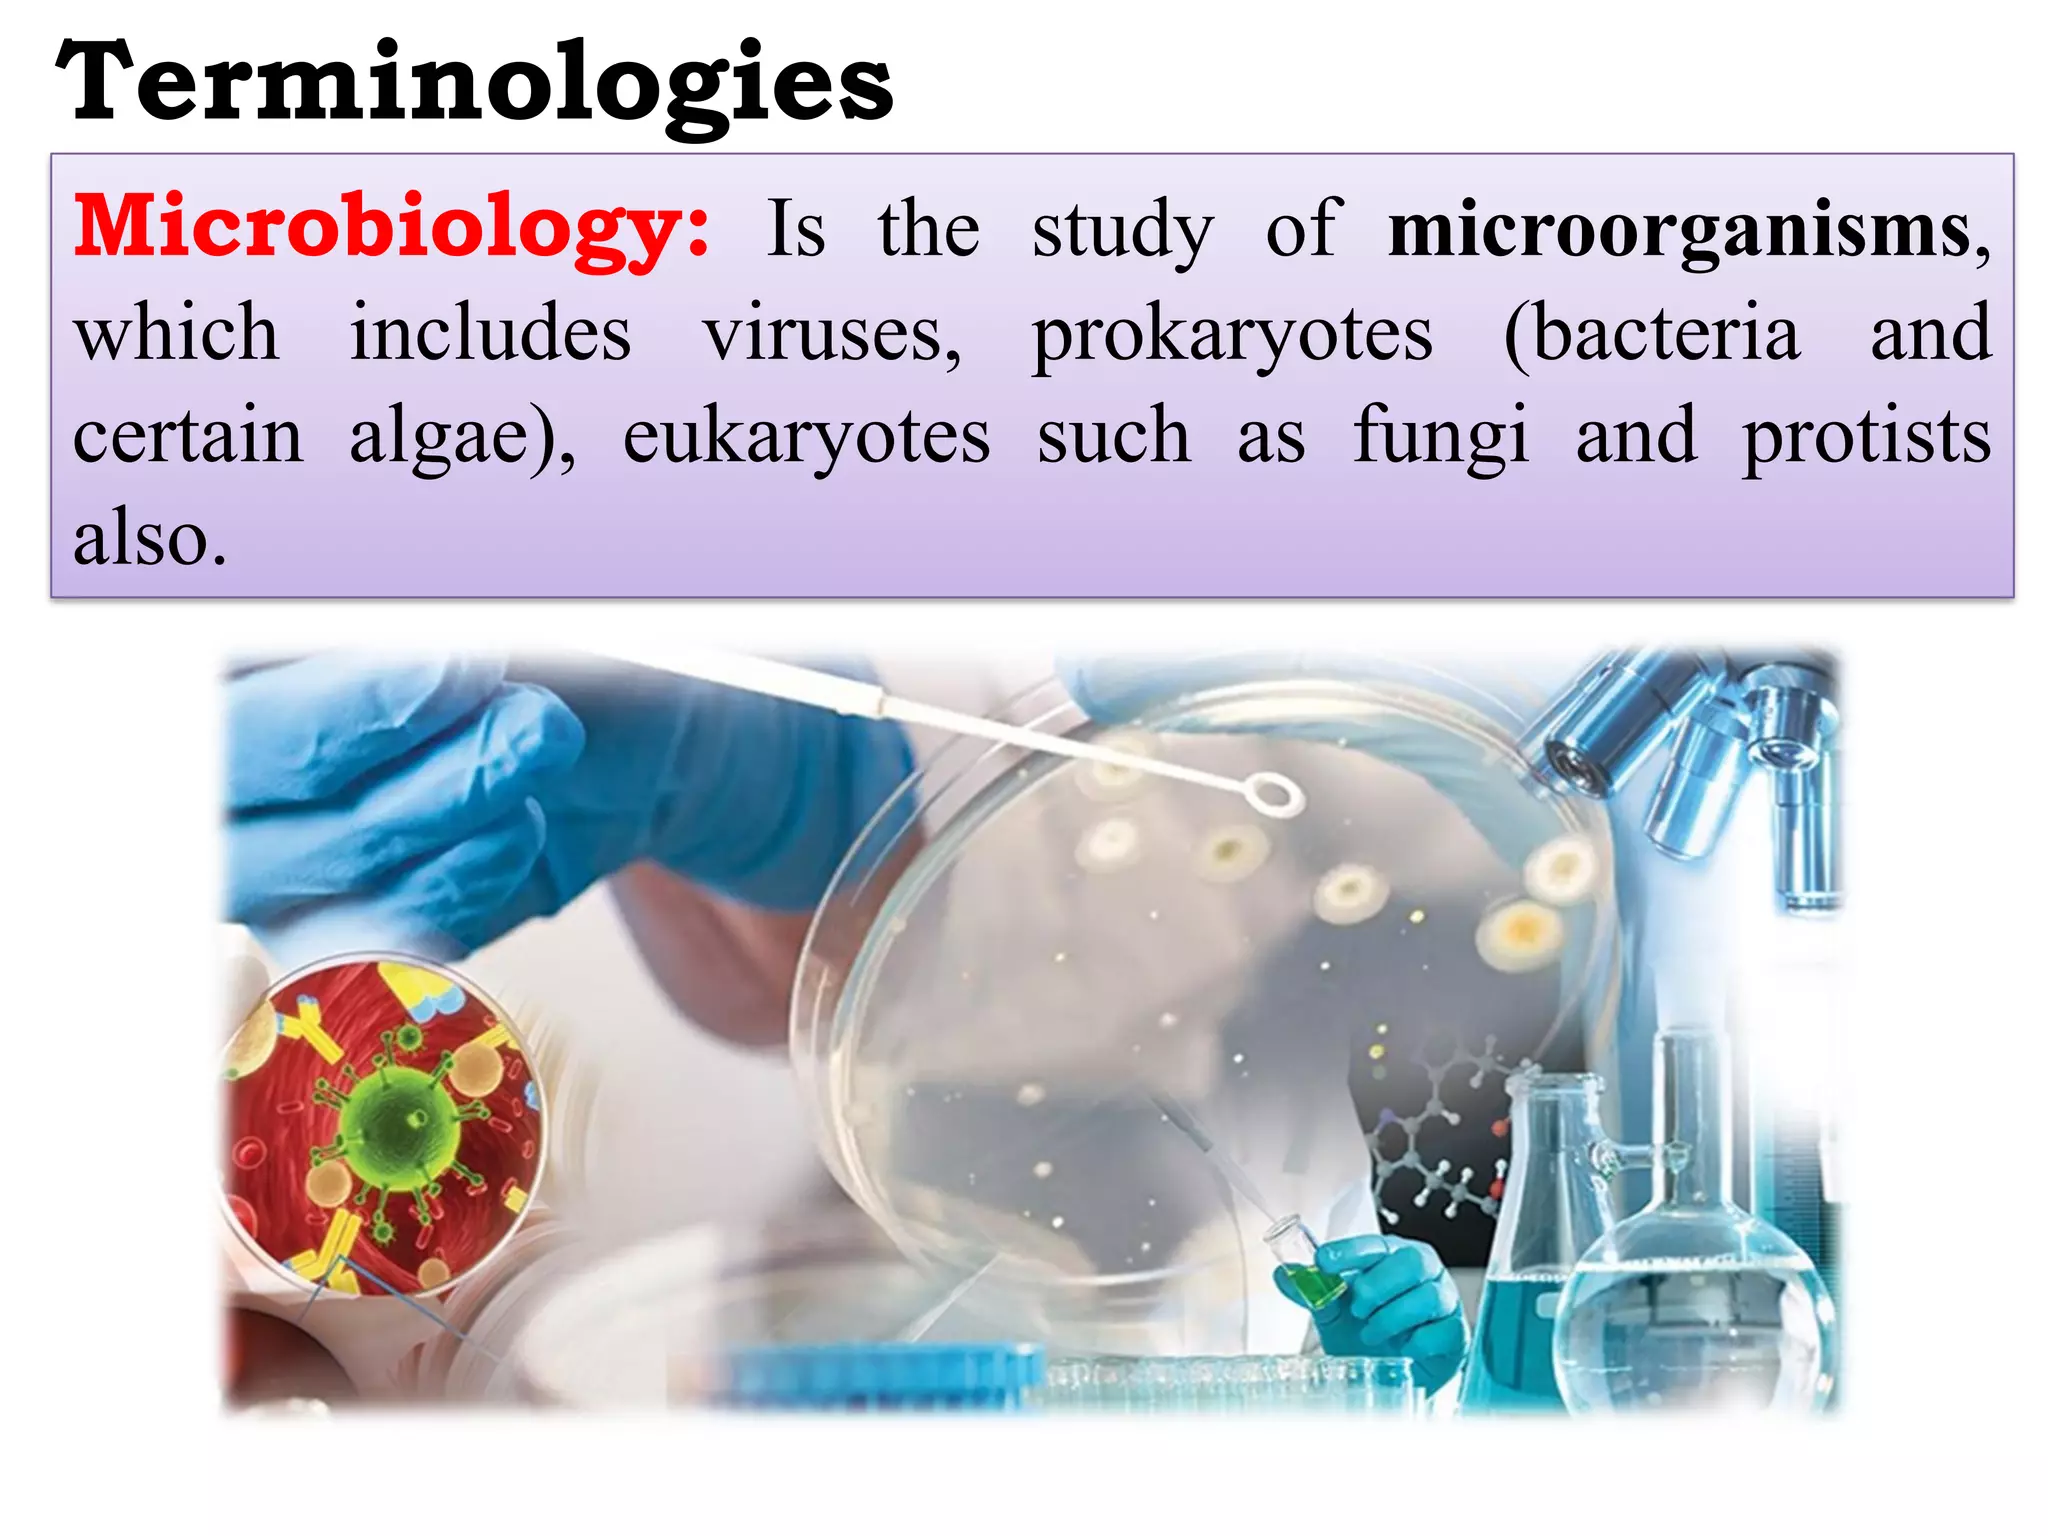
Terminologies
Microbiology: Is the study of microorganisms,
which includes viruses, prokaryotes (bacteria and
certain algae), eukaryotes such as fungi and protists
also.
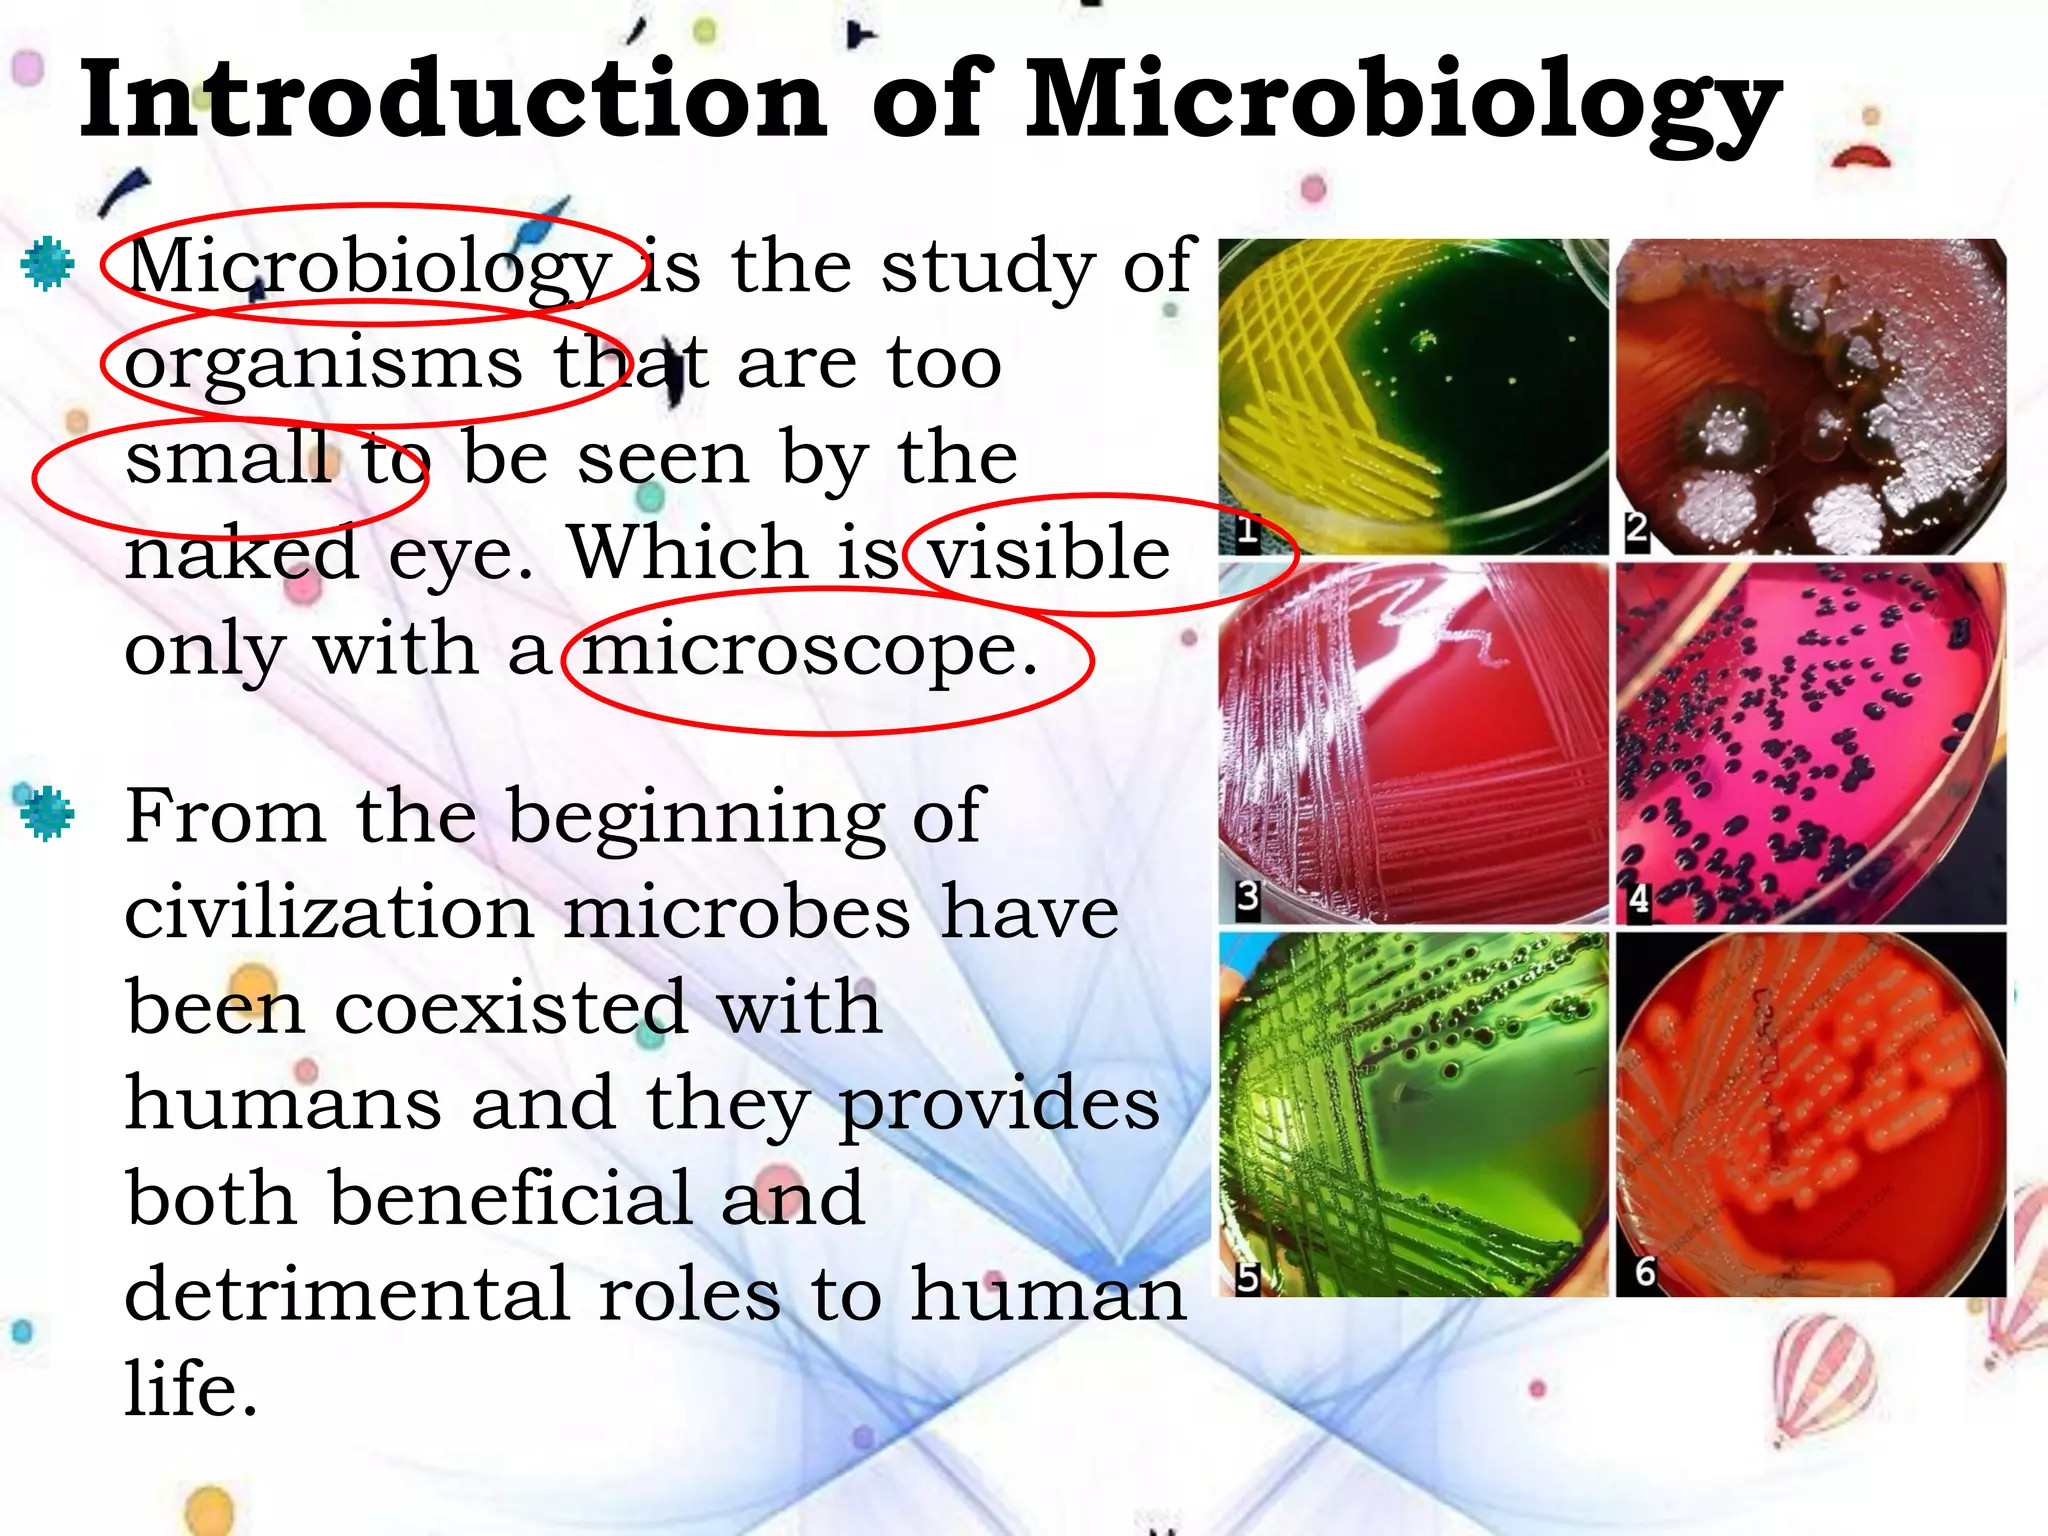
Introduction of Microbiology
Microbiology is the study of
organisms that are too
small to be seen by the
naked eye. Which is visible
only with a microscope.
From the beginning of
civilization microbes have
been coexisted with
humans and they provides
both beneficial and
detrimental roles to human
life.

Dr. Chitra Bhattacharya will be teaching a course on fundamentals of microbiology. The course will cover terminology, identification, why microbiology is studied, its history and contributions of key figures. It will discuss the omnipresence of microbes in nature and introduce concepts like microbiology, microorganisms, and microscopy. The history will be divided into the discovery, transitional, golden and modern eras highlighting figures like Aristotle, Van Leeuwenhoek, Pasteur and Fleming. The document provides definitions of key terms and an overview of the scope and content to be covered in the course.